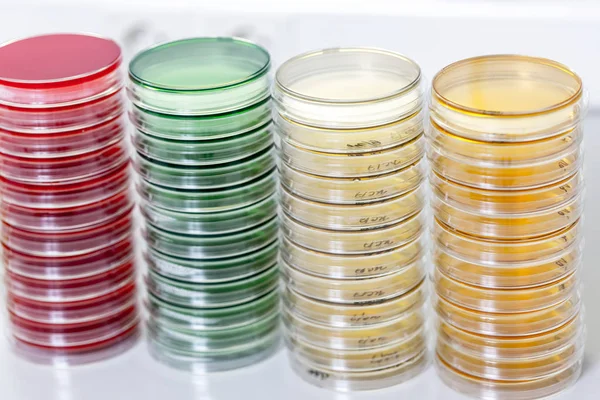
Laboratuvar masaya Petry yemekleri
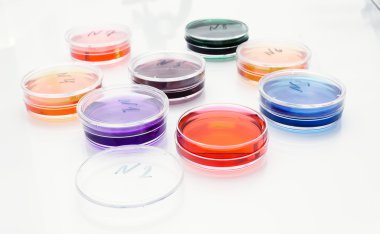
eski plastik petri yemeklerinde renkli sıvı
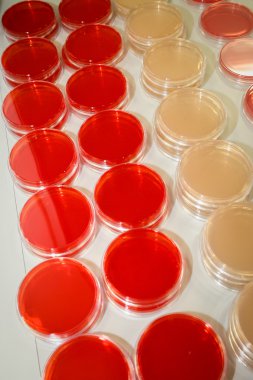
Bilim laboratuarı detayı - stok görüntü
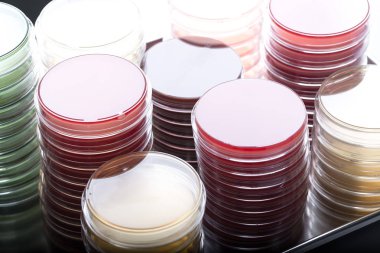
Mikrobiyoloji lab Bakteriyolojinin laboratuvar arka plan üzerinde kırmızı ve sarı petri yemekler küçük yığınlardaki.
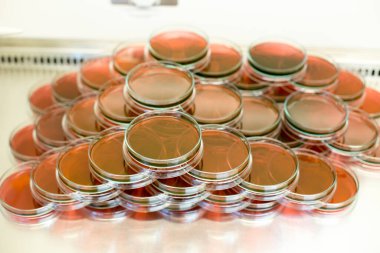
Biyolojik güvenlik dolapları laboratuvarında Inoculum testleri için kültür medyumu Eosin Metilen Blue (EMB) Agar.
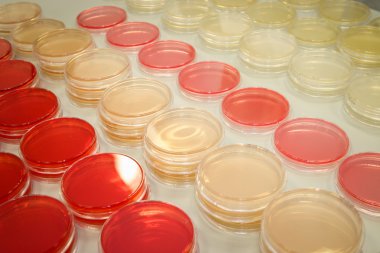
Bilim laboratuarı detayı - stok görüntü

Laboratuvar masaya Petry yemekleri
Özel Boyut
(5536 x 3691, jpg)
Geniş Lisanslama
(5536 x 3691, jpg)
En Çok Aranan Kelimeler
yeşilRenkKırmızıSarıbeyazMaviArkaplanCam.İzole edilmişŞeffafYansımadonanımSıvıSağlıkİlaç.TıbbidikkateczanetabakmahsultamAygıtKlinikÖlçümTest etTüpşişemataraSıcaklıkKimyasalDeneyCam eşyalar.LaboratuvarBilimkimyaEczacılık.UyuşturucuboyutdörtaraştırmaBilimselKapasitedayanıklıkesimireaktiflerPetriBenzer İçerikler